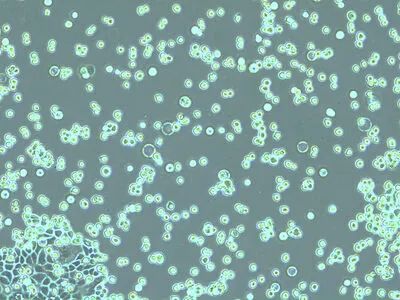

如何對細胞培養(yǎng)進行快速正確的檢測
發(fā)布時間:2023-05-04 瀏覽次數:442

本文介紹了對培養(yǎng)貼壁細胞系進行傳代的一般工作流程及步驟說明。哺乳類細胞體外培養(yǎng)是在癌癥、藥物開發(fā)、組織工程、干細胞、疾病細胞和分子生物學等生物醫(yī)學研究領域進行臨床和藥物研究的重要模型。要想成功維持細胞系,需要通過控制生長條件來維持細胞生理和表型的穩(wěn)定性。定期監(jiān)測細胞生長,對細胞進行傳代培養(yǎng)以確保連續(xù)性。
背 景
哺乳類細胞培養(yǎng)對臨床和藥物研究與應用至關重要,其可用于構建靈活的健康和疾病模型系統(tǒng)。例如在機能研究可支持電腦模擬分析并可用于替代動物模型。
細胞增殖取決于細胞類型(從動物組織分離的原代細胞、胚胎干細胞、自我更新細胞、穩(wěn)定永生化細胞系、轉化細胞)和培養(yǎng)條件(培養(yǎng)基、2D/3D細胞外基質、溫度、PH值、CO2/O2濃度)。在最佳培養(yǎng)條件下可以培養(yǎng)出用于各種實驗分析的細胞。隨著動物細胞培養(yǎng)技術的進步,細胞系逐步演變并被用于疫苗生產、治療性蛋白、藥物制劑和抗癌制劑。
要想成功維持哺乳類細胞系,必須在受控條件下培養(yǎng)細胞并使用特定培養(yǎng)基。此外,為保證細胞生理和表型的穩(wěn)定性,必須定期監(jiān)測細胞生長狀況。通常情況下,當細胞匯合度達到80%左右,須對細胞進行傳代培養(yǎng),以確保細胞生長良好且健康。細胞匯合度達80%指的是培養(yǎng)皿80%的表面被細胞所覆蓋。注意:傳代培養(yǎng)細胞的最佳匯合度取決于細胞類型且可能還需優(yōu)化。
本篇文章描述了傳代培養(yǎng)貼壁細胞系的一般工作流程并附上步驟說明和詳細圖解(見圖2)。
為何需要對細胞進行傳代?
培養(yǎng)的細胞不可能無限生長,原因在于在有限的空間內細胞數量不斷增多,營養(yǎng)物質消耗,有毒代謝物增多最終導致細胞死亡。此外,研究人員通常需要重復實驗,因此需要對培養(yǎng)細胞進行削減或擴增。經過傳代后細胞能生成相比原先密度更低的新細胞。去掉舊的培養(yǎng)基,將細胞轉移至新鮮培養(yǎng)基和基質中,補充新鮮營養(yǎng)物質并清除有毒代謝物能夠長期維持培養(yǎng)細胞。一開始接種細胞后,細胞生長進入遲滯期然后是對數生長期,此時細胞呈指數增殖,接著進入靜止期,此時細胞生長率和死亡率持平。(見圖1)。進入衰亡期,細胞因缺乏營養(yǎng)物質或培養(yǎng)條件不充足而死亡,例如細胞因匯合度過高開始爭奪生存空間。

圖1:細胞生長曲線:培養(yǎng)細胞的生長曲線包含四個階段:生長開始前的潛伏期(遲滯期)、指數增長期(對數生長期)、靜止期(細胞增殖速度逐漸減慢)、衰亡期(細胞因缺乏營養(yǎng)物質以及生存環(huán)境有問題而死亡)。應在對數生長期更換培養(yǎng)基并在進入靜止期前對細胞進行傳代培養(yǎng)。
要使細胞處于最佳培養(yǎng)條件且維持活躍增長,有必要更新培養(yǎng)基并定期進行傳代培養(yǎng)。可根據細胞類型在對數生長期多次更換培養(yǎng)基。傳代培養(yǎng)的最佳時間位于對數生長期和靜止期之間,在細胞達到密集狀態(tài)前進行。
為何需要檢查細胞?
每日以及在傳代培養(yǎng)前檢查細胞培養(yǎng)物非常重要,以此監(jiān)測細胞健康狀況、檢查污染情況、確定細胞分離時間。首先用肉眼檢查培養(yǎng)基中是否出現(xiàn)真菌污染、培養(yǎng)基渾濁度和顆粒情況,以及通過培養(yǎng)基的顏色變化發(fā)現(xiàn)意外的pH值變化。首先用肉眼檢查培養(yǎng)基中是否出現(xiàn)真菌污染、培養(yǎng)基渾濁度和顆粒情況,以及通過培養(yǎng)基的顏色變化發(fā)現(xiàn)意外的pH值變化。之后應使用倒置顯微鏡近距離檢查細胞整體形態(tài)和生長模式。倒置顯微鏡的光學元件位于樣本下方。由于細胞附著在培養(yǎng)皿底部,從底部視角便于觀察。由于正常明場照明下難以觀察到大多數細胞,因此應在100至200倍的總放大倍數和相差下進行觀察[1]。
哺乳類細胞有很多種形態(tài),但培養(yǎng)出的哺乳類細胞大多可分為3類:成纖維細胞【中國倉鼠卵巢(CHO)細胞】、上皮樣細胞【人類子宮頸(HeLa)細胞】以及淋巴樣細胞【人類白血病(HL60)細胞】。此外,某些細胞系具有特定的形態(tài)特征,例如神經細胞(SH-SY5Y)具有很長的樹突。細胞形態(tài)還受細胞生命周期活動影響。在有絲分裂過程中,許多細胞變得更圓,形成可在培養(yǎng)基中漂浮的高折射性發(fā)亮球體。死亡細胞的細胞膜完整性發(fā)生變化,細胞變得更圓,貼壁細胞從生長表面分離。在顯微鏡下,死亡細胞通常不會發(fā)亮及產生折射,它們通常的細胞膜形態(tài)可能會發(fā)生改變
不同細胞系不僅尺寸和形狀不同,生長特性也有所不同。它們要么發(fā)展成貼壁細胞(成纖維細胞和上皮細胞),要么發(fā)展成懸浮細胞(淋巴樣細胞)。大多數貼壁細胞系會生成單細胞層,附著在玻璃或經處理的塑料基板上(例如涂有聚賴氨酸、纖連蛋白、膠原蛋白或明膠)。
如何傳代培養(yǎng)細胞?
最常見的傳代細胞制備方法是使用胰蛋白酶等蛋白水解酶分解細胞間及細胞與培養(yǎng)基之間的黏合。胰蛋白酶和乙二胺四乙酸的共同作用使細胞從生長表面脫離。胰蛋白酶切斷將細胞固定在培養(yǎng)皿上的黏著斑,乙二胺四乙酸則作為鈣螯合劑。
根據細胞類型或下游實驗也可使用其他蛋白酶代替胰蛋白酶,如天然膠原酶或合成消化雞尾酒溶液等。
將參與細胞間相互作用的鈣粘蛋白中的鈣成分去掉,從而分解鈣粘蛋白,將細胞分離開來。細胞一旦失去與生長表面和周圍細胞的黏合,就能輕易分離并在新的細胞培養(yǎng)皿中生長。細胞一旦失去與生長表面和周圍細胞的黏合,就能輕易分離并在新的細胞培養(yǎng)皿中生長。圖2描述了傳代培養(yǎng)工作流程的基本步驟。在整個傳代培養(yǎng)過程中重要的是,要在無污染環(huán)境下工作。在傳代培養(yǎng)初始階段、胰蛋白酶分解過程中、細胞計數環(huán)節(jié)以及細胞分離后都要檢查細胞狀況。保持正確記錄和歸檔對于獲得一致結果和實驗追溯同樣非常重要。

圖2:傳代培養(yǎng)工作流程中標紅的步驟表示需要使用顯微鏡檢查。
以下實驗計劃給出了狗腎臟細胞在90mm有蓋培養(yǎng)皿中進行傳代培養(yǎng)的基本原則。這些細胞是從狗的遠端小管上分離的上皮細胞。在培養(yǎng)過程中,細胞貼壁生長,在實現(xiàn)匯合后形成由多邊形細胞構成的單細胞層。
需要以下材料和設備:
材料:
? 培養(yǎng)基預熱至 37° C(狗腎臟細胞需要:MEM培養(yǎng)基加5%FCS胎牛血清、2mM谷氨酰胺、100 U/mL青霉素、100 mg/mL鏈霉素);
? 預熱不含鈣鎂的PBS緩沖液;
? 在D-PBS緩沖液中預熱0.05%的胰蛋白酶、0.02%的乙二胺四乙酸;
? 臺盼藍(活體染劑);以及消毒用的70%乙醇或異丙醇。
當進行無動物源或成分明確的細胞培養(yǎng)時,使用無血清培養(yǎng)基、FBS/FCS合成替代品及非動物性解離劑。
材料:
? 帶一次性吸頭的細胞計數室移液管或微量移液管;
? 支持相差功能的倒置顯微鏡(DMi1,Mateo TL);
? 防護服和材料;
? 溫度適宜的水浴槽;
? 37°C、含5% CO2、濕度高的培養(yǎng)箱;
? 離心機;
? 離心管;
? 事先標注的培養(yǎng)皿。
狗腎臟細胞的傳代比例應為1:10。根據細胞類型調節(jié)比例。例如原代細胞培養(yǎng)物、永生化細胞系、胚胎干細胞等可能具有不同的最佳比例。
使用徠卡DMi1傳代培養(yǎng)貼壁細胞的4步工作流程
步驟1
細胞檢查
從培養(yǎng)箱中取出細胞并放在顯微鏡下快速檢查。應每天進行顯微鏡檢查,確保細胞處于健康狀態(tài)(無污染、死亡細胞少)并按預計生長。

在培養(yǎng)貼壁細胞時,細胞應主要附著在培養(yǎng)皿活燒瓶底部,培養(yǎng)基應呈粉橙色。由于培養(yǎng)基中細胞代謝物(或污染)導致酸化,因此酸堿指示劑酚紅呈黃色。由于培養(yǎng)基中細胞代謝物(或污染)導致酸化,因此酸堿指示劑酚紅呈黃色。在正常明場照明下難以觀察到這些細胞。切換至相差可以使細胞更容易被觀察到。如圖所示,使用DMi1,只需移動聚光鏡環(huán)的滑塊即可選擇相差。
記錄細胞狀態(tài)對確保各實驗結果一致十分重要。DMi1可配備攝像頭和屏幕,通過遠程控制輕松實現(xiàn)成像和保存。研究人員使用Mateo TL集成攝像頭可以拍攝細胞圖像,追蹤培養(yǎng)基狀況,將圖像轉存智能設備或U盤。

比較狗腎臟細胞在明場照明和相差圖像中的顯示效果:相差圖像的概覽效果更好,更易于檢查細胞形態(tài)和細胞計數。

步驟2
細胞提取
用移液器將培養(yǎng)基吸取至廢物容器中。也可以使用接有真空吸液器的移液器。

使用5ml不含鈣鎂的預熱PBS緩沖液仔細沖洗細胞,沖洗3次,去除殘留培養(yǎng)基中的胎牛血清。胎牛血清及其替代物會抑制胰蛋白酶。加入3ml預熱胰蛋白酶/乙二胺四乙酸,輕輕轉動培養(yǎng)皿使其均勻覆蓋培養(yǎng)皿底部的細胞。在37°C下培育幾分鐘即可傳代細胞。

不同細胞系需要的胰蛋白酶培養(yǎng)時間不同。為避免過度胰蛋白酶化使細胞受損,每隔幾分鐘在顯微鏡下檢查一次細胞。

輕柔地沖洗培養(yǎng)皿,并將細胞懸浮液轉移至50ml試管中,以800rpm的速度轉動5分鐘使細胞沉降下來。吸走上層清液并在10ml新鮮培養(yǎng)基中重懸細胞,徹底去除胰蛋白酶。

分離出的細胞應呈圓形并在胰蛋白酶溶液中自由漂浮。細胞一經分離,即向培養(yǎng)皿中加入5ml培養(yǎng)基,滅活胰蛋白酶。
步驟3
細胞計數
將100μL細胞懸浮液與等量的0.4%臺盼藍溶液混合。臺盼藍選擇性滲入死亡細胞的細胞膜并將其染藍,但不會被活細胞吸收。將蓋玻片置于計數表面上,準備好血球計。

將移液器吸嘴置于蓋玻片邊緣輕輕擠出細胞懸浮液,將其滴加在計數室上(單位面積約4μl)。蓋玻片下的整片區(qū)域發(fā)生毛細管作用。大多數情況下,計數室有兩個計數區(qū)可各自承接液體。

將計數室放在顯微鏡載物臺上并將焦點集中在細胞上。方形計數網格樣式依計數室類型而定。圖中所示的Fuchs-Rosenthal血細胞計數板有16個區(qū)域,每個區(qū)域1平方毫米,整體被線包圍。每個正方形區(qū)域被細分為16個小正方形。如圖所示,計算一個區(qū)域內16個正方形中的細胞總數。為避免重復計算位于大正方形邊線上的細胞,僅計算位于正方形兩條邊上的細胞。在本例中,觸及正方形上方和左側標紅邊線(加粗紅線)的細胞應被計入。觸及下方和右側紅色邊線的細胞應不被計入。計算計數室5個1平方毫米區(qū)域內的活細胞和死亡細胞。要計算最終結果,需要合計5個正方形的計數結果。為求得更精確的測算結果,也可以計算計數室其他正方形(大于5個)的細胞數量。
使用以下公式可計算細胞濃度:

此外還可使用細胞自動計數器。

步驟4
細胞植入
用移液器將所需細胞量(合適的細胞數量)以所需分離率(此處為1:10)吸取至新的培養(yǎng)皿中,在各培養(yǎng)皿中加入所需容積的培養(yǎng)基(10ml)。注意細胞類型、細胞分離日期以及培養(yǎng)皿蓋子上的細胞傳代次數。將細胞放回37°C培養(yǎng)箱中。

將細胞放置一晚,讓其恢復和沉降。24小時后使用顯微鏡檢查細胞形狀、黏著性及是否存在污染。

細胞應附著在培養(yǎng)皿底部并已開始生長和分裂。細胞應附著在培養(yǎng)皿底部并已開始生長和分裂。讓細胞生長直至匯合并準備好進入實驗或開始下一輪傳代培養(yǎng)。

參考文獻:
1.W. Ockenga, Phase Contrast: Making Unstained Phase Objects Visible, Science Lab (2011) Leica Microsystems.
說明:文章來源“科爾德”公眾號,轉載只為分享目的,如有侵權或不愿小編轉載發(fā)布請聯(lián)系刪除,謝謝!
